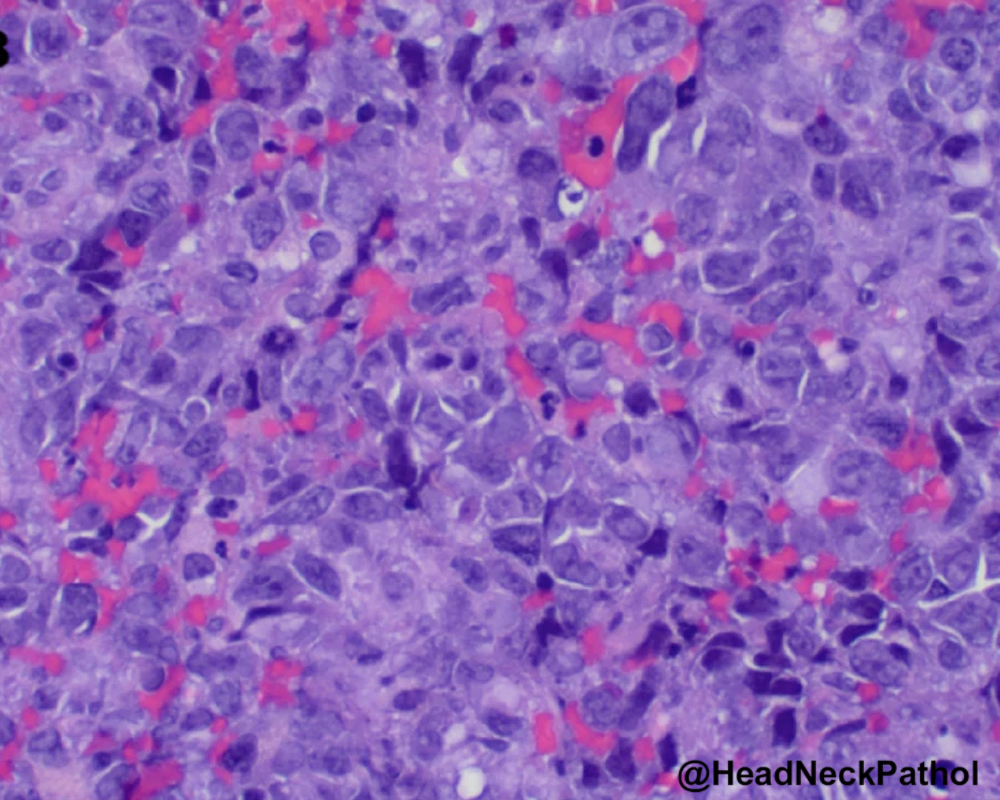
Head Neck Pathol tweet media

Intraductal Salivary Gland Neoplasms of the Oral Cavity: A Retrospective Case Series with Emphasis on Newly Described Entities
H Alshuaibi, S Neduvanchery, SG Fitzpatrick, et. al.
rdcu.be/e2mok
#HeadNeckPathol #HNPJ #HeadandNeckPath #Pathology #ENTPath #PathologyTweet



English